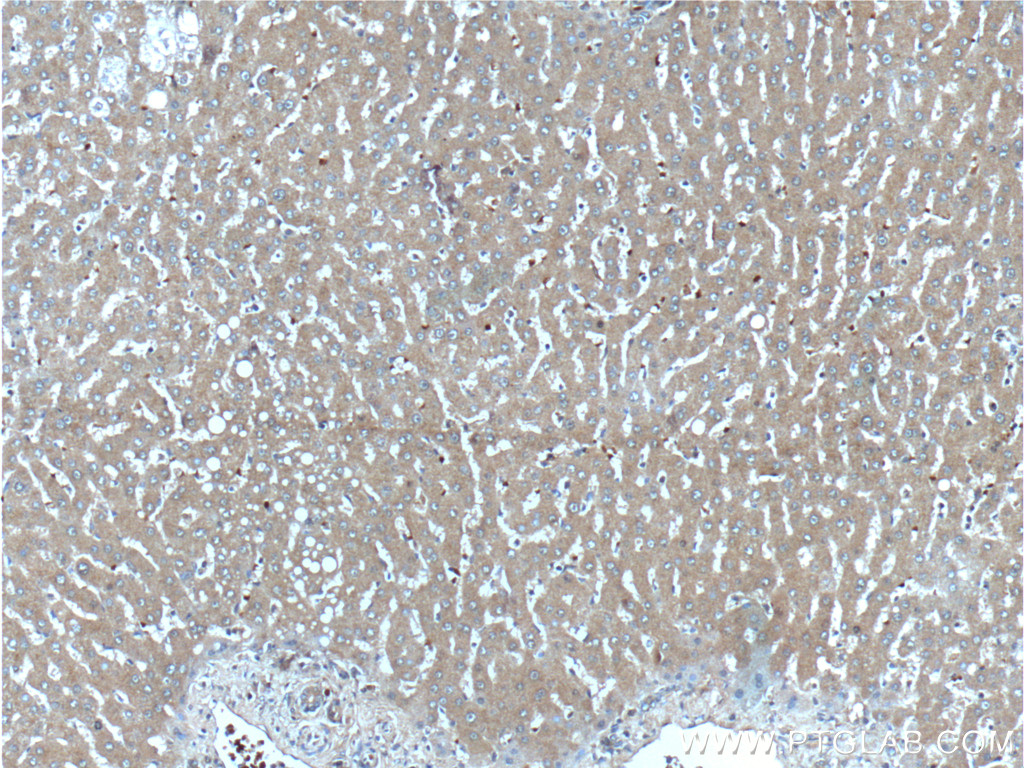

验证数据展示
经过测试的应用
| Positive WB detected in | mouse liver tissue, human milk tissue |
| Positive IHC detected in | human liver tissue, human Hepatocellular carcinoma Note: suggested antigen retrieval with TE buffer pH 9.0; (*) Alternatively, antigen retrieval may be performed with citrate buffer pH 6.0 |
推荐稀释比
| 应用 | 推荐稀释比 |
|---|---|
| Western Blot (WB) | WB : 1:200-1:1000 |
| Immunohistochemistry (IHC) | IHC : 1:50-1:500 |
| It is recommended that this reagent should be titrated in each testing system to obtain optimal results. | |
| Sample-dependent, Check data in validation data gallery. | |
产品信息
18302-1-AP targets Angiogenin in WB, IHC, IF, ELISA applications and shows reactivity with human, mouse samples.
| 经测试应用 | WB, IHC, ELISA Application Description |
| 文献引用应用 | WB, IHC, IF |
| 经测试反应性 | human, mouse |
| 文献引用反应性 | human, mouse, rat |
| 免疫原 |
Peptide 种属同源性预测 |
| 宿主/亚型 | Rabbit / IgG |
| 抗体类别 | Polyclonal |
| 产品类型 | Antibody |
| 全称 | angiogenin, ribonuclease, RNase A family, 5 |
| 别名 | ANG, ANG 1, ANG I, ANG1, ANGI |
| 计算分子量 | 17 kDa |
| 观测分子量 | 17 kDa |
| GenBank蛋白编号 | BC054880 |
| 基因名称 | Angiogenin |
| Gene ID (NCBI) | 283 |
| RRID | AB_2274028 |
| 偶联类型 | Unconjugated |
| 形式 | Liquid |
| 纯化方式 | Antigen affinity purification |
| UNIPROT ID | P03950 |
| 储存缓冲液 | PBS with 0.02% sodium azide and 50% glycerol, pH 7.3. |
| 储存条件 | Store at -20°C. Stable for one year after shipment. Aliquoting is unnecessary for -20oC storage. |
背景介绍
Angiogenin (ANG), an angiogenic ribonuclease, is a member of the vertebrate-specific, secreted RNASE superfamily. Angiogenin, originally identified as a tumor angiogenic factor, was related with the growth and metastasis of numerous tumors. Angiogenin has been proposed as a permissive factor for angiogenesis induced by other angiogenic factors, including vascular endothelial growth factor (VEGF), basic fibroblast growth factor, acidic fibroblast growth factor, and epidermal growth factor. Angiogenin production and secretion may be stimulated by hypoxia. Increased angiogenin serum levels have been associated with the incidence and severity of several human tumors, including HCC. It is a 17 kDa precursor which is cleaved to generate the 14 kDa mature protein.
实验方案
| Product Specific Protocols | |
|---|---|
| IHC protocol for Angiogenin antibody 18302-1-AP | Download protocol |
| WB protocol for Angiogenin antibody 18302-1-AP | Download protocol |
| Standard Protocols | |
|---|---|
| Click here to view our Standard Protocols |
发表文章
| Species | Application | Title |
|---|---|---|
Cell Rep Med Hyperglycemia-regulated tRNA-derived fragment tRF-3001a propels neurovascular dysfunction in diabetic mice | ||
Theranostics Transfer RNA derived fragment, tRF-Glu-CTC, aggravates the development of neovascular age-related macular degeneration | ||
Neurosci Bull The Circadian System Is Essential for the Crosstalk of VEGF-Notch-mediated Endothelial Angiogenesis in Ischemic Stroke | ||
FASEB J MicroRNA-3064-5p sponged by MALAT1 suppresses angiogenesis in human hepatocellular carcinoma by targeting the FOXA1/CD24/Src pathway. | ||
Front Oncol Forkhead Box Q1 Is Critical to Angiogenesis and Macrophage Recruitment of Colorectal Cancer. | ||
Front Med (Lausanne) Molecular and clinical characterization of ANG expression in gliomas and its association with tumor-related immune response |